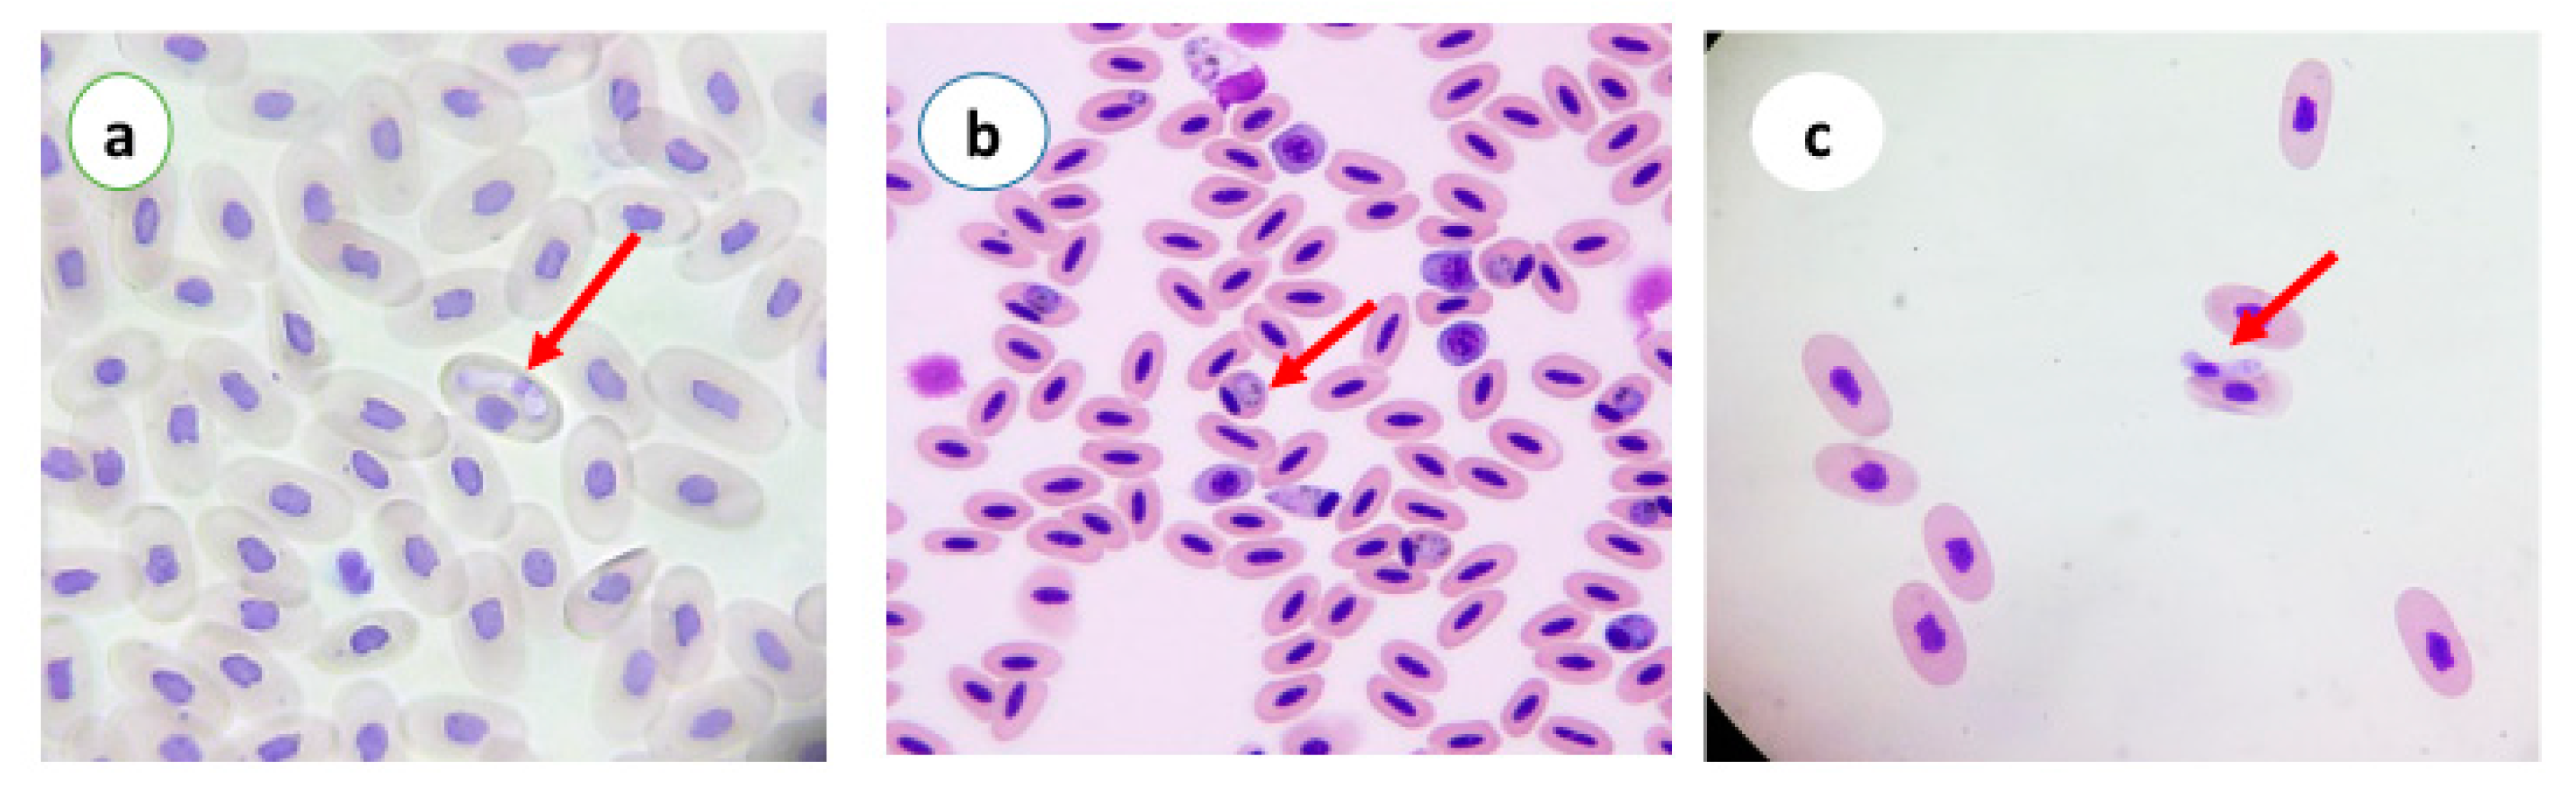
Vetsci 07 00126 g003 Vetsci 07 00126 g003

Blood Parasites in Domestic Birds in Central Iran
Abstract
1. Introduction
2. Materials and Methods
2.1. Sample Collection
2.2. Haemosporidian Parasite Detection
2.3. Statistical Analysis
3. Results
4. Discussion
5. Conclusions
Author Contributions
Funding
Acknowledgments
Conflicts of Interest
References
- Nnadi, P.; George, S. A cross-sectional survey on parasites of chickens in selected villages in the subhumid zones of South-Eastern Nigeria. J. Parasitol. Res. 2010, 2010. [Google Scholar] [CrossRef] [PubMed][Green Version]
- Valkiunas, G. Avian Malaria Parasites and Other Haemosporidia; CRC Press: Boca Raton, FL, USA, 2004. [Google Scholar]
- Zamora-Vilchis, I.; Williams, S.E.; Johnson, C.N. Environmental temperature affects prevalence of blood parasites of birds on an elevation gradient: Implications for disease in a warming climate. PLoS ONE 2012, 7, e39208. [Google Scholar] [CrossRef]
- Atkinson, C.T.; Thomas, N.J.; Hunter, D.B. Parasitic Diseases of Wild Birds; John Wiley & Sons: Hoboken, NJ, USA, 2009. [Google Scholar]
- Dimitrov, D.; Palinauskas, V.; Iezhova, T.A.; Bernotienė, R.; Ilgūnas, M.; Bukauskaitė, D.; Zehtindjiev, P.; Ilieva, M.; Shapoval, A.P.; Bolshakov, C.V. Plasmodium spp.: An experimental study on vertebrate host susceptibility to avian malaria. Exp. Parasitol. 2015, 148, 1–16. [Google Scholar] [CrossRef] [PubMed]
- Opara, M.; Osowa, D.; Maxwell, J. Blood and gastrointestinal parasites of chickens and turkeys reared in the tropical rainforest zone of southeastern Nigeria. Open J. Vet. Med. 2014, 4, 308. [Google Scholar] [CrossRef][Green Version]
- Sebaio, F.; Braga, É.M.; Branquinho, F.; Fecchio, A.; Marini, M.Â. Blood parasites in passerine birds from the Brazilian Atlantic Forest. Rev. Bras. Parasitol. Veterinária 2012, 21, 7–15. [Google Scholar] [CrossRef] [PubMed]
- Van Hemert, C.; Meixell, B.W.; Smith, M.M.; Handel, C.M. Prevalence and diversity of avian blood parasites in a resident northern passerine. Parasit. Vectors 2019, 12, 292. [Google Scholar] [CrossRef] [PubMed]
- Friend, M.; Franson, J.C.; Ciganovich, E.A. Field Manual of Wildlife Diseases: General Field Procedures and Diseases of Birds; US Geological Survey: Hunter Mill, VA, USA, 1999. [Google Scholar]
- Borji, H.; Moghaddas, E.; Razmi, G.; Bami, M.H.; Mohri, M.; Azad, M. Prevalence of pigeon haemosporidians and effect of infection on biochemical factors in Iran. J. Parasit. Dis. 2011, 35, 199–201. [Google Scholar] [CrossRef] [PubMed][Green Version]
- Dezfoulian, O.; Zibaei, M.; Nayebzadeh, H.; Haghgoo, M.; Emami-Razavi, A.; Kiani, K. Leucocytozoonosis in domestic birds in southwestern Iran: An ultrastructural study. Iran. J. Parasitol. 2013, 8, 171. [Google Scholar]
- Fecchio, A.; Marini, M.Â.; Braga, É.M. Baixa prevalência de hemoparasitos em aves silvestres no Cerrado do Brasil Central. Neotrop. Biol. Conserv. 2007, 2, 127–135. [Google Scholar]
- Fecchio, A.; Lima, M.R.; Silveira, P.; Braga, É.M.; Marini, M.Â. High prevalence of blood parasites in social birds from a neotropical savanna in Brazil. Emu-Austral Ornithol. 2011, 111, 132–138. [Google Scholar] [CrossRef]
- Gong, L.; Maiteki-Sebuguzi, C.; Rosenthal, P.J.; Hubbard, A.E.; Drakeley, C.J.; Dorsey, G.; Greenhouse, B. Evidence for both innate and acquired mechanisms of protection from Plasmodium falciparum in children with sickle cell trait. Blood 2012, 119, 3808–3814. [Google Scholar] [CrossRef] [PubMed][Green Version]
- Poulsen, J.; Permin, A.; Hindsbo, O.; Yelifari, L.; Nansen, P.; Bloch, P. Prevalence and distribution of gastro-intestinal helminths and haemoparasites in young scavenging chickens in upper eastern region of Ghana, West Africa. Prev. Vet. Med. 2000, 45, 237–245. [Google Scholar] [CrossRef]
- Njunga, G.R. Ecto-and Haemoparasites of Chickens in Malawi with Emphasis on the Effects of the Chicken Louse, Menacanthus Cornutus. Unpublished. Master’s Thesis, The Royal Veterinary and Agriculture University, Dyrlægevej, Malawi, 2003. Volume 2. [Google Scholar]
- Valkiūnas, G.; Sehgal, R.N.; Iezhova, T.A.; Smith, T.B. Further observations on the blood parasites of birds in Uganda. J. Wildl. Dis. 2005, 41, 580–587. [Google Scholar] [CrossRef][Green Version]
- Hussein, N.; Abdelrahim, E. Haemoproteus columbae infection and its histopathological effects on pigeons in Qena Governorate, Egypt. J. Pharm. Biol. Sci. (IOSRJPBS) 2016, 11, 79–90. [Google Scholar]
- Dey, A.; Begum, N.; Anisuzzaman, A.; Khan, M.; Mondal, M. Haemoprotozoan infection in ducks: Prevalence and pathology. Bangladesh J. Vet. Med. 2008, 6, 53–58. [Google Scholar] [CrossRef][Green Version]
- SENLIK, B.; GULEGEN, E.; AKYOL, V. Prevalance and intensity of haemoproteus columbae in domestic pigeons. Indian Vet. J. 2005, 82, 998–999. [Google Scholar]
- Momin, M.A.; Begum, N.; Dey, A.R.; Paran, M.S.; Alam, M.Z. Prevalence of blood protozoa in poultry in Tangail, Bangladesh. IOSR J. Agric. Vet. Sci. 2014, 7, 55–60. [Google Scholar] [CrossRef]
- Tabaripour, R.; Youssefi, M.; Rahbari, S.; Arghavan, M. Molecular identification of Haemoproteus in domestic pigeons (Colombia livia domestica) in Mazandaran province. J. Vet. Res. 2017, 72, 397–402. [Google Scholar]

| Location/Bird Types | No. | Occurrence of Haemoproteus (Haem) Parasite | Total | |||||||
|---|---|---|---|---|---|---|---|---|---|---|
| Hen | Rooster | Pigeon | Quail | Partridge | Turkey | Ostrich | Duck | |||
| Yazd | 55 | 1 (1.8) | 0 | 1 (1.8) | 0 | 0 | 0 | 0 | 0 | 2 (3.6) |
| Mehriz | 86 | 1 (1.1) | 1 (1.1) | 3 (3.5) | 0 | 0 | 1 (1.1) | 0 | 0 | 6 (6.9) |
| Taft | 70 | 3 (4.3) | 1 (1.4) | 5 (7.1) | 0 | 0 | 0 | 0 | 0 | 9 (12.8) |
| Ashkezar | 68 | 2 (2.9) | 0 | 2 (2.9) | 0 | 0 | 0 | 0 | 0 | 4 (5.8) |
| Ardakan | 56 | 0 | 0 | 2 (3.5) | 0 | 0 | 0 | 0 | 0 | 2 (3.5) |
| Total | 355 | 7 (10.1) | 2 (2.5) | 13 (18.8) | 0 | 0 | 1 (1.1) | 0 | 0 | 23 (32.6) |
| Location/Bird Types | No. | Occurrence of Plasmodium (Plas) Parasite | Total | |||||||
|---|---|---|---|---|---|---|---|---|---|---|
| Hen | Rooster | Pigeon | Quail | Partridge | Turkey | Ostrich | Duck | |||
| Yazd | 55 | 0 | 0 | 0 | 0 | 0 | 0 | 0 | 0 | 0 |
| Mehriz | 86 | 0 | 1 (1.1) | 0 | 0 | 0 | 0 | 0 | 0 | 1 (1.1) |
| Taft | 70 | 0 | 0 | 0 | 1 (1.4) | 1 (1.4) | 1 (1.4) | 0 | 0 | 3 (4.2) |
| Ashkezar | 68 | 0 | 0 | 0 | 0 | 0 | 0 | 0 | 1 (1.4) | 1 (1.4) |
| Ardakan | 56 | 0 | 0 | 0 | 0 | 0 | 0 | 0 | 1 (1.7) | 1 (1.7) |
| Total | 355 | 0 | 1 (1.1) | 0 | 1 (1.4) | 1 (1.4) | 1 (1.4) | 0 | 2 (3.1) | 6 (8.4) |
| Location/Bird Types | No. | Occurrence of Leucocytozoon (Leuc) Parasite | Total | |||||||
|---|---|---|---|---|---|---|---|---|---|---|
| Hen | Rooster | Pigeon | Quail | Partridge | Turkey | Ostrich | Duck | |||
| Yazd | 55 | 1 (1.8) | 0 | 0 | 0 | 0 | 0 | 0 | 0 | 1 (1.8) |
| Mehriz | 86 | 1 (1.1) | 0 | 1 (1.1) | 0 | 0 | 1 (1.1) | 0 | 0 | 3 (3.3) |
| Taft | 70 | 1 (1.4) | 0 | 0 | 1 (1.4) | 0 | 0 | 0 | 0 | 2 (2.8) |
| Ashkezar | 68 | 0 | 0 | 0 | 1 (1.4) | 1 (1.4) | 0 | 0 | 1 (1.4) | 3 (4.2) |
| Ardakan | 56 | 0 | 0 | 0 | 0 | 1 (1.7) | 0 | 0 | 0 | 1 (1.7) |
| Total | 355 | 3 (4.3) | 0 | 1 (1.1) | 2 (2.8) | 2 (3.1) | 1 (1.1) | 0 | 1 (1.4) | 10 (13.8) |
© 2020 by the authors. Licensee MDPI, Basel, Switzerland. This article is an open access article distributed under the terms and conditions of the Creative Commons Attribution (CC BY) license (http://creativecommons.org/licenses/by/4.0/).
Share and Cite
Mirzaei, F.; Siyadatpanah, A.; Norouzi, R.; Pournasir, S.; Nissapatorn, V.; Pereira, M.d.L. Blood Parasites in Domestic Birds in Central Iran. Vet. Sci. 2020, 7, 126. https://doi.org/10.3390/vetsci7030126
Mirzaei F, Siyadatpanah A, Norouzi R, Pournasir S, Nissapatorn V, Pereira MdL. Blood Parasites in Domestic Birds in Central Iran. Veterinary Sciences. 2020; 7(3):126. https://doi.org/10.3390/vetsci7030126
Chicago/Turabian StyleMirzaei, Farzaneh, Abolghasem Siyadatpanah, Roghayeh Norouzi, Soheila Pournasir, Veeranoot Nissapatorn, and Maria de Lourdes Pereira. 2020. "Blood Parasites in Domestic Birds in Central Iran" Veterinary Sciences 7, no. 3: 126. https://doi.org/10.3390/vetsci7030126
APA StyleMirzaei, F., Siyadatpanah, A., Norouzi, R., Pournasir, S., Nissapatorn, V., & Pereira, M. d. L. (2020). Blood Parasites in Domestic Birds in Central Iran. Veterinary Sciences, 7(3), 126. https://doi.org/10.3390/vetsci7030126

